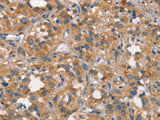
CEACAM6 Polyclonal Antibody Store at -20°C

CEACAM6 Polyclonal Antibody Store at -20°C
SKU: E-AB-12782-200
CEACAM6 Polyclonal Antibody Store at -20°C
| SKU # | E-AB-12782 |
| Reactivity | Human |
| Host | Rabbit |
| Applications | IHC |
Product Details
| Isotype | IgG |
| Host | Rabbit |
| Reactivity | Human |
| Applications | IHC |
| Clonality | Polyclonal |
| Immunogen | Synthetic peptide of human CEACAM6 |
| Abbre | CEACAM6 |
| Synonyms | CD 66c, CD66c, CD66c antigen, CEA LIKE PROTEIN, Carcinoembryonic antigen related cell adhesion molecule 6, Carcinoembryonic antigen related cell adhesion molecule 6 (non specific cross reacting antigen), Carcinoembryonic antigen-related cell adhesion molecule 6 |
| Swissprot | |
| Cellular Localization | Cell membrane. |
| Concentration | 0.6 mg/mL |
| Buffer | Phosphate buffered solution, pH 7.4, containing 0.05% stabilizer and 50% glycerol. |
| Purification Method | Affinity purification |
| Research Areas | Cancer, Tags and Cell Markers |
| Conjugation | Unconjugated |
| Storage | Store at -20°C Valid for 12 months. Avoid freeze / thaw cycles. |
| Shipping | The product is shipped with ice pack,upon receipt,store it immediately at the temperature recommended. |
Related Reagents
| Applications | Recommended Dilution |
| IHC | 1:50-1:200 |
Background
Carcinoembryonic antigen (CEA; MIM 114890) is one of the most widely used tumor markers in serum immunoassay determinations of carcinoma. An apparent lack of absolute cancer specificity for CEA probably results in part from the presence in normal and neoplastic tissues of antigens that share antigenic determinants with the 180-kD form of CEA (Barnett et al., 1988 [PubMed 3220478]). For background information on the CEA family of genes, see CEACAM1 (MIM 109770).